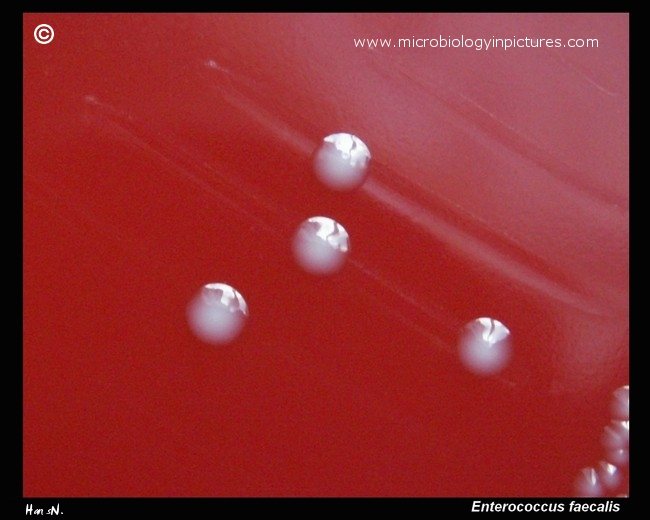

Enterococcus faecalis colonies on sheep blood agar in detail. Gamma-hemolytic colonies (no visible
changes of erythrocytes in agar medium around colonies).
Some strains of E.faecalis can grow with
alpha-hemolysis. Beta-hemolytic strains are rare. Cultivation 24 hours, 37°C in an aerobic atmosphere.